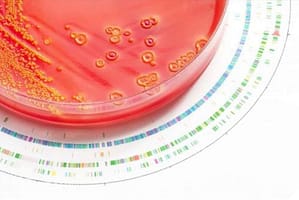
Capacidad de los laboratorios nacionales de referencia en Latinoamérica para detectar mecanismos de resistencia emergentes

Identifican a los gérmenes más comunes de otitis en América Latina
Un estudio corroboró la frecuencia de las principales bacterias que provocan otitis media aguda en América Latina y el Caribe, una enfermedad muy frecuente en niños.
Un estudio corroboró la frecuencia de las principales bacterias que provocan otitis media aguda en América Latina y el Caribe, una enfermedad muy frecuente en niños. Esa información es útil para el desarrollo de vacunas y la implementación de otras medidas para la prevención y tratamiento de esa enfermedad.
(18/07/11 – Agencia CyTA – Instituto Leloir)-. Un estudio publicado en la revista científica International Journal of Pediatric Otorhinolaryngology revela cuáles son los gérmenes más comunes de la otitis media aguda en América Latina y el Caribe, una enfermedad muy frecuente en los niños, especialmente en los primeros años de vida. Es causada por gérmenes como bacterias o virus, los que ascienden desde la faringe a través de la trompa de Eustaquio (conducto que conecta la faringe al oído medio) y se instalan en el oído medio donde causan una infección.
“Nuestro estudio contribuye al conocimiento de las causas bacterianas de otitis media aguda en niños de Latinoamérica y Caribe y ayuda a que las vacunas para prevenir esa patología se adapten al tipo de bacterias que predominan en la región”, explicó a la Agencia CyTA el autor principal del estudio, el doctor Ariel Bardach, médico clínico y epidemiólogo del Instituto de Efectividad Clínica y Sanitaria (IECS), institución sin fines de lucro con sede en la ciudad de Buenos Aires, que se dedica a la investigación, la educación y la cooperación técnica en salud.
Bardach y sus colegas del Hospital de Niños “Dr. Ricardo Gutierrez”, en Buenos Aires, y de otras instituciones científicas, analizaron los artículos científicos publicados en revistas científicas internacionales en los últimos 20 años que incluyen datos sobre chicos de 0 a 5 años de todos los países de Latinoamérica y el Caribe que padecieron otitis media aguda. “Se evaluaron en esos estudios más de 125 mil casos de niños con otitis en la región. La población de chicos incluidos en estos estudios en general fue la de pacientes de consultorios externos de pediatría u otorrinolaringología.”, puntualizó el doctor el especialista.
Ranking de bacterias
Los principales hallazgos del estudio, establecieron que el neumococo y el Haemophilus Influenzae son los dos gérmenes (bacterias) más frecuentemente implicados.
“Los tipos de neumococo más comunes fueron el 19F, 6B, 19A y 5. Esta información es de importancia para las autoridades sanitarias en cuanto a aspectos relacionados a la vacunación”, afirmó el autor principal del estudio.
De acuerdo con el investigador, la otitis media se encuentra entre los principales motivos de prescripción de antibióticos en la infancia. “Los niños que no reciben tratamiento corren el riesgo de estar predispuestos a reinfecciones o pueden desarrollar persistencia de los gérmenes que causan la enfermedad”, explicó.
Y agregó: “El riesgo de las otitis agudas radica en su reaparición. Muy raramente, sobre todo en chicos no tratados, aparecen complicaciones graves como mastoiditis (una infección del hueso mastoideo localizado detrás de la oreja) o meningitis (inflamación de las meninges, membranas que envuelven el encéfalo y la médula espinal)”. De acuerdo con la Organización Mundial de la Salud algunas complicaciones asociadas con la otitis media aguda producen cerca de 50 mil muertes al año en países en desarrollo. Habitualmente esta patología se trata con antibióticos y a veces también se requiere drenar el pus que se acumula en la caja del tímpano.”
Los síntomas más frecuentes de la otitis aguda son fiebre, y dolor de cabeza en general lateralizado al oído comprometido. “El pediatra al revisar el oído con un otoscopio constata que el tímpano está rojo y congestivo”, afirma el especialista. Y concluye: “Los padres, ante la aparición de los síntomas descriptos, deben realizar una consulta médica.”




